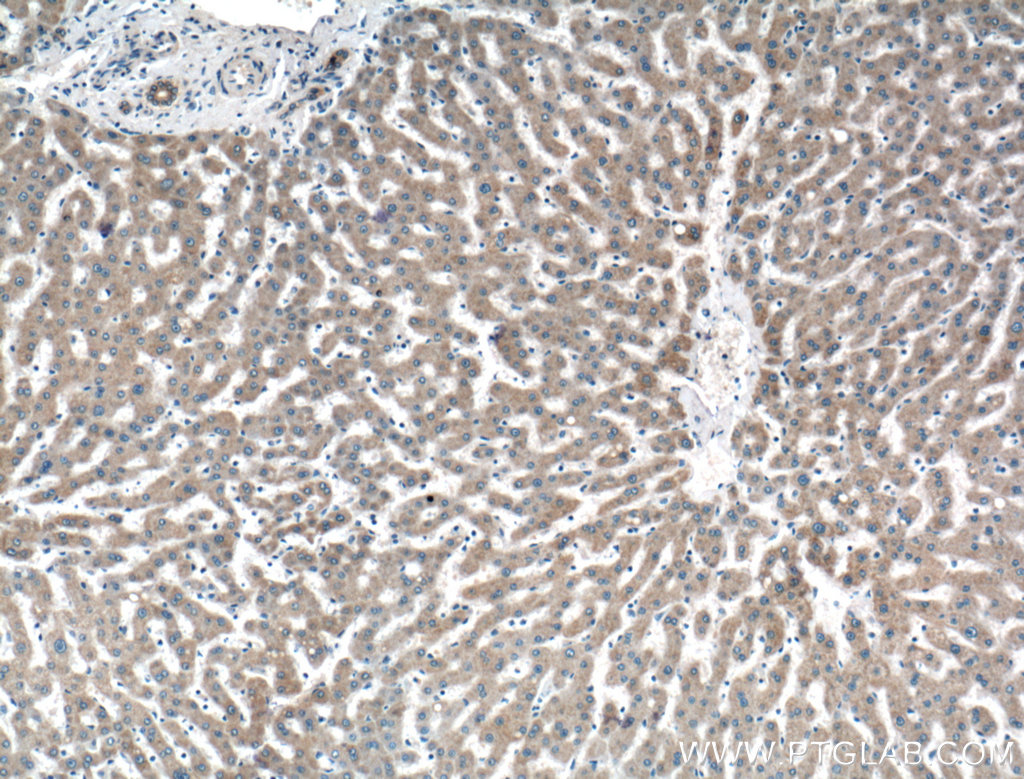

验证数据展示
经过测试的应用
| Positive WB detected in | MCF-7 cells, HeLa cells |
| Positive IHC detected in | human liver tissue Note: suggested antigen retrieval with TE buffer pH 9.0; (*) Alternatively, antigen retrieval may be performed with citrate buffer pH 6.0 |
| Positive IF/ICC detected in | HeLa cells |
推荐稀释比
| 应用 | 推荐稀释比 |
|---|---|
| Western Blot (WB) | WB : 1:500-1:2000 |
| Immunohistochemistry (IHC) | IHC : 1:50-1:500 |
| Immunofluorescence (IF)/ICC | IF/ICC : 1:50-1:500 |
| It is recommended that this reagent should be titrated in each testing system to obtain optimal results. | |
| Sample-dependent, Check data in validation data gallery. | |
产品信息
21097-1-AP targets PRAS40 in WB, IHC, IF/ICC, ELISA applications and shows reactivity with human samples.
| 经测试应用 | WB, IHC, IF/ICC, ELISA Application Description |
| 文献引用应用 | WB, IF |
| 经测试反应性 | human |
| 文献引用反应性 | human, mouse |
| 免疫原 |
CatNo: Ag15355 Product name: Recombinant human PRAS40 protein Source: e coli.-derived, PGEX-4T Tag: GST Domain: 1-256 aa of BC051844 Sequence: MASGRPEELWEAVVGAAERFRARTGTELVLLTAAPPPPPRPGPCAYAAHGRGALAEAARRCLHDIALAHRAATAARPPAPPPAPQPPSPTPSPPRPTLAREDNEEDEDEPTETETSGEQLGISDNGGLFVMDEDATLQDLPPFCESDPESTDDGSLSEETPAGPPTCSVPPASALPTQQYAKSLPVSVPVWGFKEKRTEARSSDEENGPPSSPDLDRIAASMRALVLREAEDTQVFGDLPRPRLNTSDFQKLKRKY 种属同源性预测 |
| 宿主/亚型 | Rabbit / IgG |
| 抗体类别 | Polyclonal |
| 产品类型 | Antibody |
| 全称 | AKT1 substrate 1 (proline-rich) |
| 别名 | AKT1S1, 40 kDa proline rich AKT substrate, 40 kDa proline-rich AKT substrate, Proline rich AKT1 substrate 1, Proline-rich AKT1 substrate 1 |
| 计算分子量 | 27 kDa |
| 观测分子量 | 40 kDa |
| GenBank蛋白编号 | BC051844 |
| 基因名称 | PRAS40 |
| Gene ID (NCBI) | 84335 |
| RRID | AB_2878811 |
| 偶联类型 | Unconjugated |
| 形式 | Liquid |
| 纯化方式 | Antigen affinity purification |
| UNIPROT ID | Q96B36 |
| 储存缓冲液 | PBS with 0.02% sodium azide and 50% glycerol, pH 7.3. |
| 储存条件 | Store at -20°C. Stable for one year after shipment. Aliquoting is unnecessary for -20oC storage. |
背景介绍
PRAS40 (40 kDa proline-rich AKT substrate) is also named as AKT1S1 (Proline-rich AKT1 substrate 1). PRAS40 is a substrate of Akt and a component of the mammalian target of rapamycin complex 1 (mTORC1) (PMID: 28978182). Locating at the crossroad of the PI3K/Akt pathway and the mTOR pathway, PRAS40 is phosphorylated by growth factors or other stimuli, and regulates the activation of these signaling pathways in turn (PMID: 28978182). PRAS40 is expressed in a variety of tissues in vivo and has multiple phosphorylation sites, which its activity is closely related to phosphorylation. Studies have shown that PRAS40 is involved in regulating cell growth, cell apoptosis, oxidative stress, autophagy and angiogenesis, as well as various of signalling pathways such as mammalian target of mammalian target rapamycin (mTOR), protein kinase B (PKB/Akt), nuclear factor kappa-B(NF-κB) proto-oncogene serine/threonine-protein kinase PIM-1(PIM1) and pyruvate kinase M2 (PKM2) (PMID: 33504218).
实验方案
| Product Specific Protocols | |
|---|---|
| IF protocol for PRAS40 antibody 21097-1-AP | Download protocol |
| IHC protocol for PRAS40 antibody 21097-1-AP | Download protocol |
| WB protocol for PRAS40 antibody 21097-1-AP | Download protocol |
| Standard Protocols | |
|---|---|
| Click here to view our Standard Protocols |
发表文章
| Species | Application | Title |
|---|---|---|
Nat Commun Hypothalamic SLC7A14 accounts for aging-reduced lipolysis in white adipose tissue of male mice | ||
J Neuroinflammation Sexually dimorphic extracellular vesicle responses after chronic spinal cord injury are associated with neuroinflammation and neurodegeneration in the aged brain | ||
Front Oncol The Molecular Landscape and Biological Alterations Induced by PRAS40-Knockout in Head and Neck Squamous Cell Carcinoma.
| ||
Mol Cell Oncol Silencing Glypican-1 enhances the antitumor effects of Pictilisib via downregulating PI3K/Akt/ERK signaling in chemo-resistant esophageal adenocarcinoma |